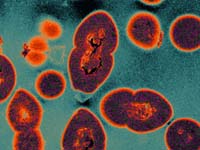
an image of an infection with the Vancomycin-Resistant Enterococcus bacteria

|
 |
Vancomycin-Resistant Enterococcus
Vancomycin-resistant enterococci is a strain of the genus Enterococcus resistant to the antibiotic vancomycin. Enterococci, is a species of bacteria that are present in some women digestive tract, and genital usually. Enterococci, can lead infection of the blood flow, the urinary tract. Some people carry the bacteria, but it was not affected by it. These people, "said colony". It is possible when caused enterococcal infection, are treated with an antibiotic vancomycin. Recently, based on the VRE enterococci, or vancomycin-resistant enterococci, and is resistant to vancomycin therapy. There are mainly responsible for Enterococcus and VRE include enterococci organisms both.

History and biology of VRE
In order to become resistant to vancomycin, usually enterococci sensitive to vancomycin, and generates a new DNA in the form of a transposon or plasmid encoding a gene conferring resistance to vancomycin. It, E. casseliflavus and Garinarumu to be distinguished from the lower level of natural resistance to vancomycin some enterococcal species, including E. thing to win the vancomycin resistance. E. faecium clinical isolates and high-level vancomycin-resistant E. faecalis, has been documented in Europe in the late 1980s for the first time. Since then, VRE is associated with infection in the (hospital) worldwide occurrence of the hospital. In the United States, vancomycin-resistant E. faecium is associated with a 4% of hospital-acquired infections reported to Centers for Disease Control and Prevention National Healthcare Safety Network from January 2006 from October 2007. VRE may be prepared from healthy human in contact with bacteria. It is believed that carrying VRE also a significant proportion of breeding chickens intensive, although such contact, it places most likely to occur in hospitals (nosocomial infections).
Risk Factors & Transmission
According to the Centers for Disease Control and Preventio, people at risk for acquiring VRE include:
- People who have been treated with antibiotics or other antibiotics vancomycin for a long time
- People admitted in hospitals, particularly those who are in the hospital or if you receive treatment with antibiotics over a long period of time
- People with immune systems weakened as a transplant patient ward and ICU and cancer, such as people
- People who have undergone surgical procedures, such as heart surgery and abdominal such people
- For example the cost of medical devices remaining within a certain time or intravenous urinary catheters, such as (IV) catheters,
- Who are colonized with VRE
VRE is, you can find blood, urine, and feces. Therefore, in many cases, and is transmitted through the hands of providers passed the "bug" to other patient unconsciously and take care of VRE patient. VRE can be transferred to the patient from the patient. VRE can be able to live for a few weeks on the surface counter, bed rail, such as door handles such, to be sent by contact with the surface of these.

Treatment and clinical symptoms
Clinical symptoms of VRE depends on the site of infection. If the bacteria are located in the urine, the symptoms of urinary tract infections, low back pain, urgency, frequency, and including pain urination, it will become apparent. If the bacteria is infected with a wound area, usually, swelling, redness, and I show signs other common wound infection. VRE infection patients, you can have other signs of infection high temperature, fever, and diarrhea. Identified by clinical examination once, VRE may be treated antibiotics, ampicillin or penicillin G is preferred. However, new drugs such as tigecycline, linezolid, or Dapto such, if resistant VRE strains to ampicillin or penicillin G may be necessary. The infectious disease specialist, should be consulted to determine the best care plan for patients with VRE. In other patients, or VRE infection patient is placed on the site of a private with a VRE. The health service needs to take extra precautions to prevent the spread of bacteria to other inpatient
GENTAUR Belgium BVBA BE0473327336 Voortstraat 49, 1910 Kampenhout BELGIUM Tel 0032 16 58 90 45 Fax 0032 16 50 90 45 info@gentaur.com GENTAUR Ltd. GB111298832 Howard Frank Turnberry House 1404-1410 High Road Whetstone London N20 9BH Tel 020 3393 8531 Fax 020 8445 9411 |
GENTAUR France SARL FR63484237888 9, rue Lagrange, 75005 Paris Tel 01 43 25 01 50 Fax 01 43 25 01 60 RCS Paris B 484 237 888 SIRET 48423788800017 RIB 30004 00187 00010092253 10 BNP PARIBAS PARIS PL MAUBERT BIC BNPAFRPPPRG IBAN FR76 3000 4001 8700 0100 9225 310 france@gentaur.com |
GENTAUR GmbH DE815175831 Marienbongard 20 52062 Aachen Deutschland de@gentaur.com Tel 0241 95 78 94 78 Tacka Vancheva Tel logistics 0241 4008 9086 Annick Verdeyen Fax 0241 55 91 05 36 Bankleitzahl 39050000 IBAN DE8839050000107569353 Handelsregister Aachen HRB16058 Steuernummer 201/5961/3925 de@gentaur.com |
GENTAUR Nederland BV NL850396268B01 Kuiper 1 5521 DG Eersel Nederland KVK nummer 52327027 Tel: 0208-080893 Fax: 0497-517897 nl@gentaur.com IBAN: NL04RABO0156985462 SWIFT RABONL2U GENTAUR Ltd. GB111298832 Howard Frank Turnberry House 1404-1410 High Road Whetstone London N20 9BH Tel 020 3393 8531 Fax 020 8445 9411 |
GENTAUR U.S.A Genprice Inc, Logistics 547, Yurok Circle San Jose, CA 95123 Phone: (408) 472-2934 Fax:(408) 416-3994 Phone (718)513-2983 sales@genprice.com Genprice Inc, Invoices and accounting 6017 Snell Ave San Jose, CA 95123 |
GENTAUR Italy 20135 Milano Tel 0236006593 Fax 0350085071 italia@gentaur.com GENTAUR Spain tel:0911876558 spain@gentaur.com GENTAUR BULGARIA BG20135893153, Graf Ignatiev Str. ent.V, fl. 2 Sofia 1000 Tel 0035929830070 Fax 0035929830072 sofia@gentaur.com |
ГЕНТАУЪР БЪЛГАРИЯ ID # 201 358 931 BULSTAT София 1000 ул. "Граф Игнатиев" 53 вх. В, ет. 2 Tel 0035929830070 Fax 0035929830072 e-mail: Sofia@gentaur.com IBAN: BG11FINV91501014771636 BIC: FINVBGSF |
Other countries Österreich +43720880899 Canada Montreal +15149077481 Ceská republika Praha +420246019719 Danmark +4569918806 Finland Helsset +358942419041 Magyarország Budapest +3619980547 Ireland Dublin +35316526556 Luxembourg +35220880274 Norge Oslo +4721031366 Sverige Stockholm +46852503438 Schweiz Züri +41435006251 US New York +17185132983 |